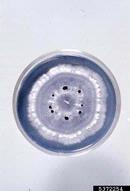

Linda Haugen, USDA Forest Service, Bugwood.org

Linda Haugen, USDA Forest Service, Bugwood.org

Linda Haugen, USDA Forest Service, Bugwood.org

Linda Haugen, USDA Forest Service, Bugwood.org

H C Ellis, University of Georgia, Bugwood.org

Mary Ann Hansen, Virginia Polytechnic Institute and State University, Bugwood.org

Florida Division of Plant Industry , Florida Department of Agriculture and Consumer Services, Bugwood.org

Florida Division of Plant Industry , Florida Department of Agriculture and Consumer Services, Bugwood.org

Florida Division of Plant Industry , Florida Department of Agriculture and Consumer Services, Bugwood.org

Florida Division of Plant Industry , Florida Department of Agriculture and Consumer Services, Bugwood.org

Florida Division of Plant Industry , Florida Department of Agriculture and Consumer Services, Bugwood.org

Florida Division of Plant Industry , Florida Department of Agriculture and Consumer Services, Bugwood.org
Florida Division of Plant Industry , Florida Department of Agriculture and Consumer Services, Bugwood.org